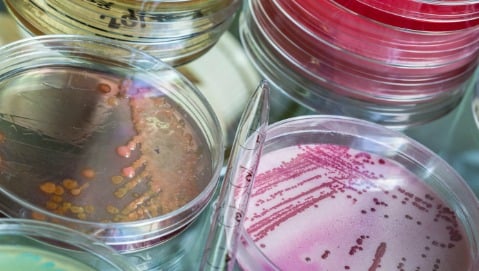

L’Organizzazione Mondiale della Sanità è sostanzialmente ottimista. «I casi di tubercolosi nel mondo stanno diminuendo ed è ipotizzabile che possa sparire entro il 2050», ha affermato Mario Ravaglione, direttore del programma tubercolosi dell’Oms, nel corso dell’ultimo congresso della Società Italiana di malattie infettive e tropicali (Simit). L’attualità, però, riferisce i casi di resistenza batterica alla base degli episodi di malattia causati dal bacillo di Koch. È troppo ottimistica la previsione del massimo ente sanitario mondiale alla luce dei casi di malattia che annualmente ritornano anche in Italia?
IL RAPPORTO DELL’OMS
Quasi nove milioni di nuove diagnosi, 1,2 milioni di morti: i numeri della tubercolosi dell’ultimo anno non lascerebbero ben sperare, ma in realtà sono in calo rispetto al 2011 e agli anni precedenti. Tra le malattie infettive, fa più vittime soltanto l’Aids. Eppure c’è quasi da sfregarsi le mani, se si considera che nel 1990 moriva quasi il 45% in più dei malati e che l’obiettivo di dimezzare i decessi entro il 2015 si avvicina. «Ma anche l’Oms sa che sarà quasi impossibile stare nei tempi - afferma Luigi Codecasa, direttore del centro di controllo della tubercolosi della Lombardia di Villa Marelli del Niguarda -. Il vero problema è la resistenza ai farmaci. Il fenomeno, ancora poco quantificabile, lascia spesso inermi di fronte alla malattia e contribuisce ad aumentare un altro avvenimento: quello delle mancate diagnosi». Nell’ultimo rapporto sulla malattia, stilato dall’Oms dopo aver esaminato i dati provenienti da 178 Paesi nel mondo, gli specialisti hanno sottolineato come, a fronte di 22 milioni di pazienti curati, 450mila hanno sviluppato forme di resistenza.
LE PROSPETTIVE
A poco meno di un secolo dalla scoperta del vaccino Bcg, in Italia ormai quasi del tutto inutilizzato e considerato poco efficace, non si è ancora trovata un’alternativa efficace. Il micobacterium tubercolosis, infatti, ha una struttura abbastanza complessa non ancora determinata al punto da poter affrontarla con successo. Nel frattempo, per sconfiggere il fenomeno della resistenza agli antibiotici, aumentano i farmaci sul mercato. Per eradicare l’infezione, però, occorrerà mettere a punto un nuovo vaccino: traguardo lontano, per adesso.
GLI ULTIMI CASI DI MILANO
Cinque ragazzi, due universitari e tre adolescenti, colpiti dalla tubercolosi in pieno inverno: a Milano s’è tornato a parlare di emergenza, ma in realtà i numeri delle infezioni nelle città metropolitane sono sempre più alti. «I casi non sono tanti - prosegue Codecasa -, ma li notiamo perché l’Italia è un Paese a endemia bassa in cui si pensa che l’infezione sia ormai un ricordo del passato». Se eventuali casi di contagio tra gli adulti non destano troppe preoccupazioni, quando si parla dei giovani le attenzioni crescono. Solitamente il batterio parte da un adulto e, pur avendo rintracciato il caso indice, a Milano gli specialisti stanno ancora scavando per capire chi abbia contagiato questo ragazzo. Nel dubbio, però, valgono le precauzioni di sempre: tenere spesso le finestre aperte, dare la giusta aria e una buona quantità di luce all’ambiente sono piccoli trucchi per ridurre la trasmissione delle malattia.